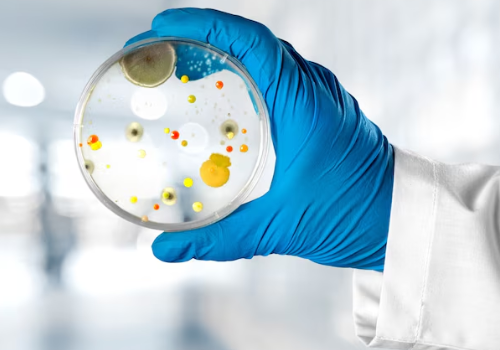

OVERVIEW

Goals
The broad goal of the teaching of undergraduate students in Microbiology is to provide an understanding of the natural history of infectious disease in order to deal with the etiology, pathologenesis, laboratory diagnosis, treatment and control of infections in the community.
OBJECTIVES

Knowledge
At the end of the course, the student should be able to:
-
State the infective micro-organisms of the human body and describe the host parasite relationship.
-
List pathogenic micro-organisms (bacteria, viruses, parasites, fungi) and describe the pathogenesis of the diseases produced by them.
-
State or indicate the modes of transmission of pathogenic and opportunistic organisms and their sources, including insect vectors responsible for transmission of infection.
-
Describe the mechanisms of immunity to infections.
-
Acquire knowledge on suitable antimicrobial agents for treatment of infections and scope of immunotherapy and different vaccines available for prevention of communicable diseases.
-
Apply methods of disinfection and sterilization to control and prevent hospital and community acquired infections.
-
Recommend laboratory investigations regarding bacteriological examination of food, water, milk and air.

Skills
At the end of the course, the student should be able to:
-
Plan and interpret laboratory investigations for the diagnosis of infectious diseases and to correlate the clinical manifestations with the etiological agent.
-
Identify the common infectious agents with the help of laboratory procedures and use antimicrobial sensitivity tests to select suitable antimicrobial agents.
-
Perform commonly employed bed-side tests for detection of infectious agents such as blood film for malaria, filaria, gram staining and AFB staining and stool sample for ova cyst.
-
Use the correct method of collection, storage and transport of clinical material for microbiological investigations.



